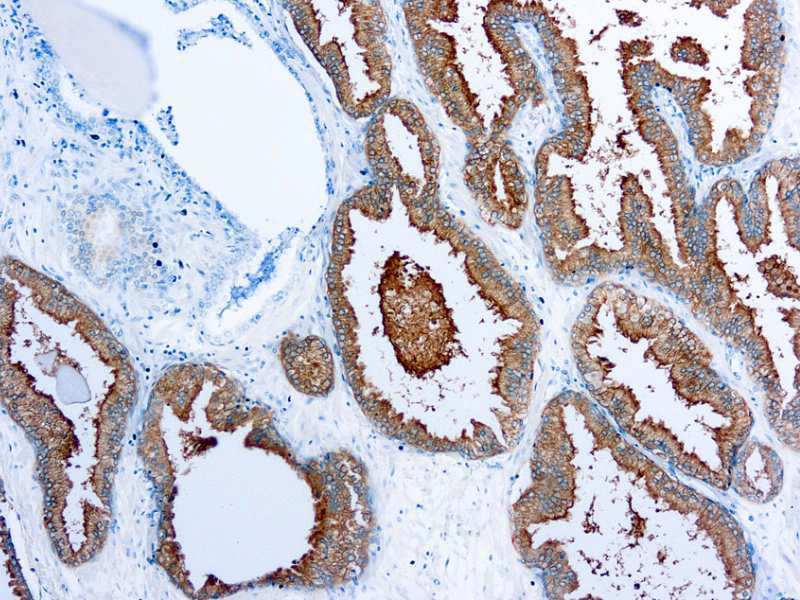

Prostate Specific Antigen (PSA)
SKU: 8514
Categories: Primary Antibodies, RUO - Outside U.S. Market
Tags: HL72K-Core Kit, Concentrated, P, Highlighter Product
Description
This antibody reacts with human prostate specific antigen.
Additional information
| Catalog No. | Mob548R Concentrated, PDM548R Prediluted |
|---|---|
| Clone | 35H9 |
| Isotype | IgG1 |
| Immunogen | Prokaryotic recombinant protein corresponding to a portion of the N-terminus of the prostate specific antigen molecule. |
| Species | Mouse |
| Cellular Localization | Cytoplasmic |
| Positive Control Tissue | Prostate carcinoma |
| Pretreatment | Citrate Buffer pH 6.0 |
| Incubation & Temperature | 30 min @ RT |
| Intended Use | IVD, RUO |
| Detection System | PolyVue Plus – Two Step Detection System or Montage PolyVue Plus Auto Detection System for Montage 360 System |
| Description/Type | Mouse Monoclonal Antibody |
| Format | This product is supplied as a tissue culture supernatant and contains sodium azide as a preservative. |
DATASHEETS & SDS
REFERENCES
REFERENCES
- National committee for Clinical Laboratory Standards (NCCLS)
Villanova, P.A 1991; 7(9) - Fenoglio-Preiser C, Wolf CM, Rilke F, Field & Wood Inc.,
Philadelphia - Nadji M, Morales AR, Laboratory Medicine, 1983; 14:767
Reviews (0)
Only logged in customers who have purchased this product may leave a review.

Reviews
There are no reviews yet.